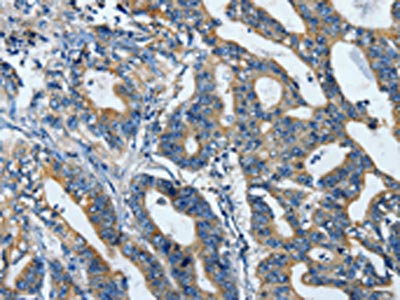

TLR4 Antibody
-
中文名稱:TLR4兔多克隆抗體
-
貨號(hào):CSB-PA902590
-
規(guī)格:¥1100
-
圖片:
-
The image is immunohistochemistry of paraffin-embedded human liver cancer tissue using CSB-PA902590(TLR4 Antibody) at dilution 1/25. (Original magnification: ×200)
-
The image is immunohistochemistry of paraffin-embedded human gastric cancer tissue using CSB-PA902590(TLR4 Antibody) at dilution 1/25. (Original magnification: ×200)
-
Gel: 6%SDS-PAGE, Lysate: 60 μg, Lane: K562 cells, Primary antibody: CSB-PA902590(TLR4 Antibody) at dilution 1/550, Secondary antibody: Goat anti rabbit IgG at 1/8000 dilution, Exposure time: 1 minute
-
-
其他:
產(chǎn)品詳情
-
Uniprot No.:
-
基因名:
-
別名:ARMD10 antibody; CD284 antibody; CD284 antigen antibody; ESOP 1 antibody; ESOP1 antibody; Homolog of Drosophila toll antibody; hToll antibody; LY 96 antibody; LY96 antibody; Lymphocyte antigen 96 antibody; md 2 antibody; MD 2 protein antibody; MD2 protein antibody; Myeloid differentiation protein 2 antibody; Protein MD 2 antibody; Protein MD2 antibody; TLR 4 antibody; TLR4 antibody; TLR4_HUMAN antibody; TOLL antibody; Toll like receptor 4 antibody; Toll-like receptor 4 antibody
-
宿主:Rabbit
-
反應(yīng)種屬:Human,Mouse,Rat
-
免疫原:Fusion protein of Human TLR4
-
免疫原種屬:Homo sapiens (Human)
-
標(biāo)記方式:Non-conjugated
-
抗體亞型:IgG
-
純化方式:Antigen affinity purification
-
濃度:It differs from different batches. Please contact us to confirm it.
-
保存緩沖液:-20°C, pH7.4 PBS, 0.05% NaN3, 40% Glycerol
-
產(chǎn)品提供形式:Liquid
-
應(yīng)用范圍:ELISA,WB,IHC
-
推薦稀釋比:
Application Recommended Dilution ELISA 1:2000-1:5000 WB 1:500-1:2000 IHC 1:25-1:100 -
Protocols:
-
儲(chǔ)存條件:Rabbit IgG in phosphate buffered saline , pH 7.4, 150mM NaCl, 0.02% sodium azide and 50% glycerol.
-
貨期:Basically, we can dispatch the products out in 1-3 working days after receiving your orders. Delivery time maybe differs from different purchasing way or location, please kindly consult your local distributors for specific delivery time.
-
用途:For Research Use Only. Not for use in diagnostic or therapeutic procedures.
引用文獻(xiàn)
- Spatiotemporal expression patterns of ZBP1 in the brain of mouse experimental stroke model T Mutoh,Journal of chemical neuroanatomy,2023
相關(guān)產(chǎn)品
靶點(diǎn)詳情
-
功能:Cooperates with LY96 and CD14 to mediate the innate immune response to bacterial lipopolysaccharide (LPS). Acts via MYD88, TIRAP and TRAF6, leading to NF-kappa-B activation, cytokine secretion and the inflammatory response. Also involved in LPS-independent inflammatory responses triggered by free fatty acids, such as palmitate, and Ni(2+). Responses triggered by Ni(2+) require non-conserved histidines and are, therefore, species-specific. Both M.tuberculosis HSP70 (dnaK) and HSP65 (groEL-2) act via this protein to stimulate NF-kappa-B expression. In complex with TLR6, promotes sterile inflammation in monocytes/macrophages in response to oxidized low-density lipoprotein (oxLDL) or amyloid-beta 42. In this context, the initial signal is provided by oxLDL- or amyloid-beta 42-binding to CD36. This event induces the formation of a heterodimer of TLR4 and TLR6, which is rapidly internalized and triggers inflammatory response, leading to the NF-kappa-B-dependent production of CXCL1, CXCL2 and CCL9 cytokines, via MYD88 signaling pathway, and CCL5 cytokine, via TICAM1 signaling pathway, as well as IL1B secretion. Binds electronegative LDL (LDL(-)) and mediates the cytokine release induced by LDL(-). Stimulation of monocytes in vitro with M.tuberculosis PstS1 induces p38 MAPK and ERK1/2 activation primarily via TLR2, but also partially via this receptor. Activated by the signaling pathway regulator NMI which acts as damage-associated molecular patterns (DAMPs) in response to cell injury or pathogen invasion, therefore promoting nuclear factor NF-kappa-B activation.
-
基因功能參考文獻(xiàn):
- the presence of polymorphism Asp299Gly gene TLR4 in patients co-infected with HIV/HCV indicates a high risk of metabolic disturbances PMID: 30204113
- high expression of (TLR4) is associated with Type 2 diabetes mellitus. PMID: 30403590
- Data suggest that the toll-like receptor 4 (TLR4) mutant-specific conformational alterations may help in deciphering the mechanism of loss-of-function mutations. PMID: 28272553
- TLR4 and TLR9 mRNA were elevated in blood samples from celiac disease patients compared to the healthy controls PMID: 30057921
- high TLR4 expression level during acute rejection was associated with adverse kidney allograft outcome PMID: 29475090
- the results of the present study showed significantly higher mRNA expression levels for TLR4 180days post-transplantation in the graft dysfunction group compared to well functioning graft group PMID: 29452169
- the expression levels of TLR4/MyD88 were positively correlated with the metastatic potential of breast cancer cells and tumors. The expression levels of TLR4/MyD88 may be used as a biomarker to evaluate the prognosis and guide the treatment of patients with breast cancer. PMID: 30066873
- These results suggest that celastrol exerts its protective effect partly via inhibiting the TLR4mediated immune and inflammatory response in steatotic HepG2 cells. PMID: 30015859
- No association between the SNPs rs10983755 A/G, rs4986791 C/T, rs4986790 A/G, rs10759932 C/T, rs1927911 C/T, rs11536889 C/G, and rs12377632 C/T and heart transplant rejection was found PMID: 30177119
- The results revealed that TLR4 and COX-2 were upregulated in PCa tissues; silencing of TLR4 or COX-2 inhibited PCa cell proliferation, migration, and invasion. PMID: 30098292
- The role of IDO1-IDO2-AHR pathway in the TLR4-induced tolerogenic phenotype in human dendritic cells has been reported. PMID: 28256612
- TLR4 Asp299Gly polymorphism potentially leading to the development of recurrent hydatidosis, by skewing the immune system towards a Th2 response PMID: 29602972
- Study demonstrated that HMGB1 and TLR4 could contribute to the inflammatory lichen planus process in skin. PMID: 29728859
- Physical interaction between p38 and eNOS was demonstrated by immunoprecipitation, suggesting a novel, NO-independent mechanism for eNOS regulation of TLR4. In correlation, biopsy samples in patients with systemic lupus erythematous showed reduced eNOS expression with associated elevations in TLR4 and p38, suggesting an in vivo link. PMID: 29061842
- The overexpression of miR-140 inhibited the upregulation of the expression of TLR4. PMID: 29901170
- TLR4 small interfering RNA blocked hUGT1A1/hNRs downregulation. PMID: 29311138
- The expression of TLR4 in perihematoma tissue began to increase within 6 hours after intracerebral hemorrhage and decreased after 72 hours. PMID: 29990607
- miR-20a could negatively regulate TLR4 and NLRP3 signaling to protect human aortic endothelial cells from inflammatory injuries. PMID: 29653364
- Study provides clear evidence that resistin is a clinically relevant endogenous ligand for TLR4, which promotes tumor progression via TLR4/NF-kappaB/STAT3 signaling. PMID: 28991224
- The antitumor effect of curcumin was related to the inhibition HSP70-TLR4 signaling. PMID: 29901164
- Activates the NFkappaB pathway through the Tolllike receptor 4 (TLR4)/myeloid differentiation factor 88 (MyD88)/IkappaBalpha axis. PMID: 29916535
- An MRP-TLR4 dependent signaling may play an important role in the pathogenesis of autoimmune thyroid diseases. PMID: 29656212
- The pathways involved in the effect of ROCK1 in human corneal epithelial cells was preliminarily explained by detecting changes of TLR4-mediated NF-kB and ERK signaling. PMID: 29804125
- Serum TLR4 was closely related to AA and associated with some AA-related circulating markers PMID: 29649455
- Fibrinogen induced podocyte injury via the TLR4-p38 MAPK-NF-kappaB p65 pathway in focal segmental glomerulosclerosis. PMID: 28407405
- Crosstalk between TLR4 and Notch1 signaling regulates the inflammatory response in the IgAN and maybe plays an important role in the progression of IgAN. PMID: 29230705
- Data indicate three sites within tenascin-C that directly and cooperatively interact with toll-like receptor 4 (TLR4). PMID: 29150600
- Low TLR4 expression is associated with pancreatic ductal adenocarcinoma. PMID: 30246618
- An association exists between P. gingivalis and P. intermedia with increased TLR-4 and NF-kappaB expression in the placenta of pre-eclamptic women with periodontitis. PMID: 28349674
- TLR4 SNPs were not associated with acute graft rejection in kidney transplant recipients. PMID: 28411360
- TLR4 Thr399Ile polymorphism was associated with increased risk of Crohn's disease in Asia and Asians. [meta-analysis] PMID: 29421805
- Our results indicated TLR4 SNP rs11536889 may be a marker for intracranial aneurysm risk PMID: 29754966
- the expression of TLR4 in gingival tissues and on mast cells increased with the severity of chronic periodontitis, suggesting that TLR4, particularly mast cell TLR4, may be important in the disease process of human chronic periodontitis. PMID: 29488617
- Report shows that rheumatoid arthritis (RA) patients express functional TLR4 on peripheral CD8+ T cells that directly promote T-cell function and differentiation to Tc1. The study also suggests that TLR4 signals directly drive Tc1 development and T cell activation independent of TCR engagement. PMID: 28424490
- Resistin promoted lung adenocarcinoma metastasis through the TLR4/Src/EGFR/PI3K/NF-kappaB pathway. PMID: 29927028
- imcreased TLR4 expression in gastric cardia lesions may be associated with gastric cardia cancer tumorigenesis PMID: 29670922
- The immunoenhancement effect of PSP against lung cancer is mediated by TLR4-MAPK/NF-kappaB signaling pathways PMID: 29343453
- LPS stimulation induced TLR4 expression and increased pigmentation. TLR4 expression was not detected after single-dose UVA or UVB treatment, but pigmentation increased. Repeated UV treatment induced TLR4 expression and increased pigmentation. LPS stimulation and repeated UV treatment increased IL-6 secretion, and repeated UVB treatment increased IL-10 secretion. PMID: 29063638
- data suggest that high-phosphate conditions directly induce vascular calcification via the activation of TLR4/NF-kappaB signaling in VSMCs PMID: 29227975
- LncRNA MEG3 ameliorates respiratory syncytial virus infection by suppressing TLR4 signaling. PMID: 29257348
- Study shows that the toll-like receptor 4 gene rs1927914 polymorphism was associated with susceptibility to ischemic stroke in males. Moreover, the rs10759932 polymorphism may affect inflammatory response in ischemic stroke patients. PMID: 29075930
- There was no difference found in MMP-2, MMP-9 or TLR-4 levels between non-thrombocytopenic and thrombocytopenic septic donors. PLA formation was increased in thrombocytopenic patients. PMID: 29734352
- there was a negative correlation between YKL-40 and TLR4 expression in chronic sinusitis patients with nasal polyps. YKL-40 and TLR4 interacted with each other to activate NF-kappaB and promote disease progression. PMID: 29921378
- High expression of MMP-9 and TLR4 in patients with COPD may promote inflammatory cell infiltration, induce proliferation of smooth muscle cells, degrade extracellular matrix, and play an important role in lung revascularization. PMID: 28537664
- our findings confirm that in south Tunisian patients with IBD, the TLR4-Thr399Ile variant is strongly associated with susceptibility to CD and that the two polymorphisms of this receptor (TLR4-Thr399Ile and TLR4-Asp299Gly) may play a role in the clinical expression of UC. PMID: 29055077
- Logistic analysis showed that both rs11536889 and rs7873784 in TLR4 were associated with risk of type-2 diabetes mellitus (T2DM) complicated by tuberculosis (TB) (T2DMTB) in additive and dominant models. Carriers with homozygous and heterozygous mutants of rs11536889 and rs7873784 were associated with higher T2DMTB risk than those with wild-type homozygotes PMID: 29073942
- Involvement of the TLR-4 in the mediation of the biglycan action was confirmed using a specific silent agent (siRNA). Taken together, these data could be used to develop new anti-inflammatory approaches PMID: 29339093
- TLR4 was significantly up-regulated in synovial tissue samples from rheumatoid arthritis patients. PMID: 28987944
- The results revealed a lack of association for TLR4 variant with ischemic stroke and hemorrhagic stroke, although a significant association was observed with the subtypes extracranial large artery. PMID: 28963650
- TREM-2 promotes acquired cholesteatoma-induced bone destruction by modulating TLR4 signaling pathway and osteoclasts activation PMID: 27934908
顯示更多
收起更多
-
亞細(xì)胞定位:Cell membrane; Single-pass type I membrane protein. Early endosome. Cell projection, ruffle.
-
蛋白家族:Toll-like receptor family
-
組織特異性:Highly expressed in placenta, spleen and peripheral blood leukocytes. Detected in monocytes, macrophages, dendritic cells and several types of T-cells.
-
數(shù)據(jù)庫(kù)鏈接:
Most popular with customers
-
-
YWHAB Recombinant Monoclonal Antibody
Applications: ELISA, WB, IHC, IF, FC
Species Reactivity: Human, Mouse, Rat
-
Phospho-YAP1 (S127) Recombinant Monoclonal Antibody
Applications: ELISA, WB, IHC
Species Reactivity: Human
-
-
-
-
-